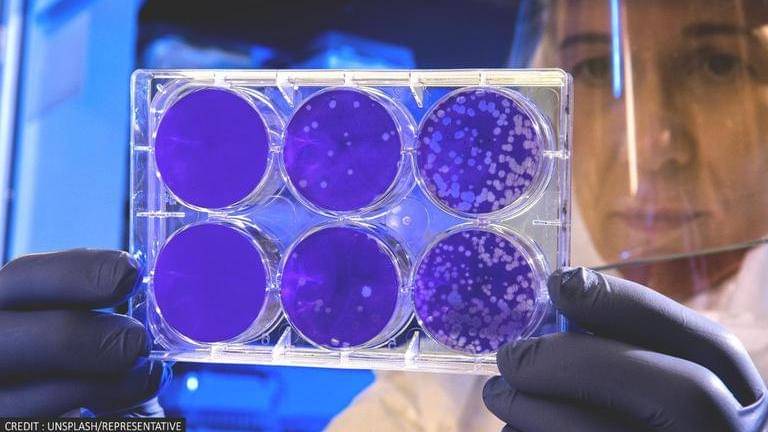

Climate change can fuel spread of flesh-eating parasite in North America, scientists warn
Scientists have warned that Leishmaniasis, a disease caused by a flesh-eating parasite, can spread in North American areas as a result of climate change.
- World News
- 2 min read
Scientists have recently warned that Leishmaniasis, a disease caused by a flesh-eating parasite, can spread in North American areas as a result of climate change. According to Undark Magazine, the disease is caused by a parasite known as Leishmania, which eats the flesh of the host infected by it. Leishmaniasis is already endemic to about 92 countries in the world with about two million cases each year, of which 70,000 people die.
As per the reports, the disease already exists in tropical and subtropical countries like Brazil, Mexico, and India. The parasites are also currently endemic in Texas and Oklahoma and new studies suggest that they might be present in other states, including Florida. The scientists have said that while reported cases of leishmaniasis contracted in the US are currently negligible, they may soon be on the rise. They explained that as climate change pushes rodent and sand fly habitat northward, an increasing number of US residents could be exposed to different varieties of flesh-eating parasite.
According to scientists, a person can get infected with the disease if they are bitten by infected sand flies. They explained that parasites infect sandflies when they feed on infected rodents’ blood. Further, they also cautioned that some strains of Leishmania parasites can be life-threatening.
Symptoms of leishmaniasis
Symptoms of the disease include lesions to ulcers on the visible parts of the body such as arms, legs and face. Another variant of the disease can cause irregular intense periods of fever, weight loss, swollen spleen and liver and serious anaemia. Some variants of the disease can be treated using gentle treatment but treating it as bacterial infections can make it severe. Sometimes the disease heals on its own.
Advertisement
Meanwhile, in 2007 the World Health Organization added leishmaniasis to the list of neglected tropical diseases, which mainly affect the world’s poor and do not receive much attention. A 2010 study also raised an alarm that by 2020 the disease-causing parasite was expected to reach many US states. Scientists have also predicted that by 2080, it will put nearly 27 million North Americans at risk of infection. However, it is worth noting that there is a vaccine under clinical trial that showed positive results in its first stage and scientists claim that the new vaccine can safely stimulate an immune response linked to a cure.
